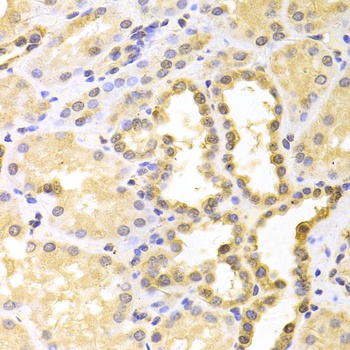
产品细节图片3

相关产品推荐更多 >
万千商家帮你免费找货
0 人在求购买到急需产品
- 详细信息
- 文献和实验
- 技术资料
- 抗体名:
S100A11 Antibody, KO Validated抗体
- 抗体英文名:
S100A11 Antibody, KO Validated
- 靶点:
S100A11
- 浓度:
batch dependent
- 应用范围:
IF, IHC, WB
- 适应物种:
Human
- 保质期:
6-12个月
- 抗原来源:
详询
- 目录编号:
orb1274450
- 级别:
科研级
- 库存:
88
- 供应商:
biorbyt
- 标记物:
Unconjugated
- 克隆性:
Polyclonal
- 形态:
Liquid
- 亚型:
IgG
- 免疫原:
Recombinant fusion protein containing a sequence corresponding to amino acids 1-105 of human S100A11 (NP_005611.1).
- 规格:
100 ul
别名:HEL-S-43, MLN7S100C, protein S100-A11, MLN 7calgizzarin, epididymis secretory protein Li 43, metastatic lymph node gene 70 protein, protein S100-C
免疫原:Recombinant fusion protein containing a sequence corresponding to amino acids 1-105 of human S100A11 (NP_005611.1).
分子量:Observed: 12kDa
应用注释:WB: 1:500 - 1:2000IHC: 1:50 - 1:200IF: 1:50 - 1:200
防腐剂:Liquid
纯化:Affinity 纯化
保存说明:Maintain refrigerated at 2-8°C for up to 2 weeks. For long term storage store at -20°C in small aliquots to prevent freeze-thaw cycles.
UniProt ID:P31949
Note:For research use only.

风险提示:丁香通仅作为第三方平台,为商家信息发布提供平台空间。用户咨询产品时请注意保护个人信息及财产安全,合理判断,谨慎选购商品,商家和用户对交易行为负责。对于医疗器械类产品,请先查证核实企业经营资质和医疗器械产品注册证情况。
文献和实验双特异抗体(Bispecific antibody)的简介和制作方法
、双特异抗体简介双特异抗体(Bispecific antibody)是含有两个不同配体结合位点的免疫球蛋白分子。自然状态下不存在双特异性抗体,只能通过特殊方法进行制备。以往双特异抗体的制备方法有化学交联法,杂合F(ab')2 分子法和鼠杂交瘤法等。化学交联法生产双特异抗体的异源性,批与批之间的不稳定性,以及抗体特异性易受某些修饰或不当连接而改变的特性,使得该法生产的双特异抗体不适于体内使用。以巯基交联蛋白酶消化片断F(ab')生产的双特异杂交分子,成分虽较均一,但费时费力,且产量很低。杂交瘤法生产
Methods 2016 年的文章2,国际抗体验证工作小组(International Working Group on Antibody Validation, IWGAV)提出 5 种支柱策略(conceptual pillar),如下:1. 基因策略(敲除验证):利用 CRISPR/Cas 或 RNAi 等技术对靶基因进行敲除(knock out)或敲低(knock down),分别检测对照组与 KO 组的信号。2. 正交策略:在多种样品中使用一种与抗体无关的定量方法,然后比较分析基于抗体的定量
Improving Phage Display Throughput by Using Hyperphage, Miniaturized Titration and pVIII (g8p) ELISA
Hyperphage is a substitute for M13KO7 helper phage used in antibody phage display. It allows to improve the antibody display efficiency on phage by 2-3 orders of magnitude. This is achieved by forcing the packaging E. coli cell to exclusively
技术资料暂无技术资料 索取技术资料






![CHD3 Rabbit mAb [KD Validated]抗体,orb1726731,biorbyt](https://img1.dxycdn.com/p/s14/2025/1208/587/0021103303578387991.jpg!wh200)



